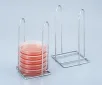
AS ONE Petri Dish Stand, 페트리디쉬 스탠드

AS ONE Ultra Long Spatula, 초대형 스패츌러
상품 한눈에 보기
산성 및 알칼리 세제에 강한 내화학성 소재로 제작된 초대형 스패츌러입니다. -20~+230℃의 넓은 온도 범위에서 사용 가능하며, 조제 탱크 내 교반 작업에 적합합니다. 손잡이는 스테인리스, 주걱부는 실리콘 재질입니다.
브랜드: AS ONE
✨AI 추천 연관 상품
AI가 분석한 이 상품과 연관된 추천 상품들을 확인해보세요
연관 상품을 찾고 있습니다...
특징
- 산성 및 알칼리성 세제에 강하며, 유지 등에 의한 변형이나 변색이 없습니다.
- 사용 온도 범위: -20~+230℃로 폭넓게 활용 가능합니다.
- 조제 탱크 내 교반 등 다양한 실험 및 제조 작업에 적합합니다.
사양
| 구분 | 재질 |
|---|---|
| 손잡이 | 스테인리스(SUS430) |
| 주걱부 | 실리콘 수지 |
🏷️AS ONE 상품 둘러보기
동일 브랜드의 다른 상품들을 확인해보세요
배송/결제/교환/반품 안내
배송 정보
| 기본 배송비 |
| 교환/반품 배송비 |
|
|---|---|---|---|
| 착불 배송비 |
| ||
| 교환/반품 배송비 |
| ||
결제 및 환불 안내
| 결제수단 |
|
|---|---|
| 취소 |
|
| 반품 |
|
| 환급 |
|
교환 및 반품 접수
| 교환 및 반품 접수 기한 |
|
|---|---|
| 교환 및 반품 접수가 가능한 경우 |
|
| 교환 및 반품 접수가 불가능한 경우 |
|
교환 및 반품 신청
| 교환 절차 |
|
|---|---|
| 반품 절차 |
|
문의 0
로그인 후 문의를 할 수 있습니다.